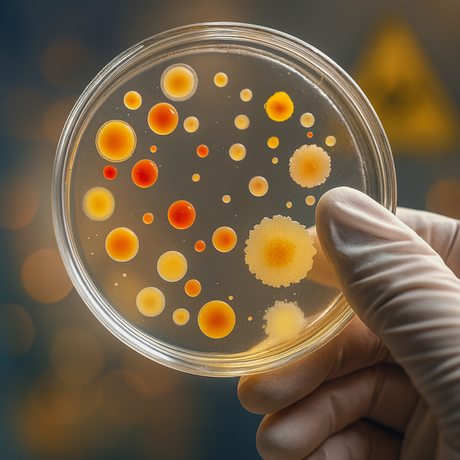

Interessierst du dich dafür, was in unseren Zellen passiert und wie unser Körper eigentlich funktioniert? Möchtest du selbst im Labor experimentieren, Proben vorbereiten und unter dem Mikroskop beobachten, was dabei passiert? Willst du verstehen, wie Krankheiten entstehen, wie man sie erkennt und welche modernen Methoden dafür eingesetzt werden? Interessiert es dich, wie man Ergebnisse sauber auswertet und dabei verantwortungsvoll mit Ethik im Gesundheitsbereich umgeht?
Dann bist du hier genau richtig. Im Schwerpunkt BioScience forschst du, denkst wie eine Wissenschaftlerin/ein Wissenschaftler und setzt Projekte gemeinsam im Team um.
Unser vertiefendes Angebot für dich:
-
Anatomie & Physiologie
Du lernst, wie unser Körper funktioniert, vom Blutkreislauf bis zum Nervensystem. -
Biochemie & Molekularbiologie
Du untersuchst, wie Zellen Energie gewinnen, Proteine entstehen und Stoffwechselwege funktionieren. Durch geeignete Versuche im Labor machst du diese Prozesse sichtbar. -
Genetik & Immunologie
Du analysierst DNA, erkennst genetische Muster und verstehst, wie das Immunsystem auf Erreger reagiert. Das Spektrum reicht dabei von Impfprinzipien bis zur Autoimmunität. -
Mikrobiologie & Hygiene
Du arbeitest mit Mikroorganismen, lernst sterile Technik und beurteilst Keimbelastungen. -
Biotechnologie & Personalisierte Medizin
Du lernst Methoden wie PCR/Elektrophorese kennen und verstehst, wie Therapien zunehmend auf einzelne Patient*innen zugeschnitten werden.
Stundentafel:
Abteilungsvorstand
Tel.Nr.: 0662/453610-500
Raum: A 212 (Trakt A, 2. Stock)
Werkstättenleiter
Tel.: 0662/453610-510
Raum: G 112 (1. Stock, Trakt G)